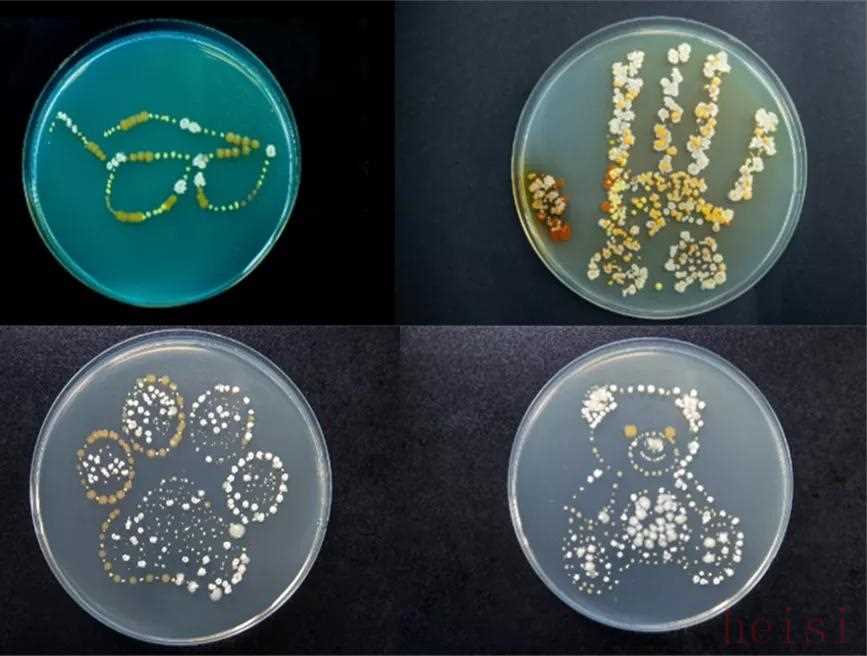

從抄襲的陰影中“突圍”并建立起成功的原創(chuàng)品牌,并非易事,這背后往往凝聚了深刻的戰(zhàn)略思考、堅(jiān)韌的執(zhí)行力和獨(dú)特的品牌魅力。這些品牌之所以能夠成功,通常在以下幾個方面做得特別到位:
1.  "深度挖掘并強(qiáng)化獨(dú)特性 (Deeply Digging into and Strengthening Uniqueness):"
       "尋找差異化:" 它們不僅僅是模仿外觀或功能,而是深入挖掘產(chǎn)品或服務(wù)的核心價值,找到市場中未被滿足的需求或獨(dú)特的切入點(diǎn)。這種差異化可以是技術(shù)創(chuàng)新、設(shè)計理念、品牌故事、用戶體驗(yàn)、材料工藝、商業(yè)模式等。
       "打造“唯一性”:" 通過持續(xù)的投入和創(chuàng)新,將某個特質(zhì)做到極致,形成難以復(fù)制的核心競爭力,讓消費(fèi)者清晰地認(rèn)識到“這就是它,與其他不同”。
2.  "構(gòu)建強(qiáng)大的品牌文化和故事 (Building a Strong Brand Culture and Story):"
       "講好品牌故事:" 挖掘品牌背后的創(chuàng)始人故事、品牌理念、價值觀,賦予品牌情感和靈魂。一個引人入勝、能夠引發(fā)共鳴的故事能有效吸引和留住消費(fèi)者。
       "塑造獨(dú)特文化:" 圍繞品牌核心價值,建立獨(dú)特的品牌文化,影響用戶行為和認(rèn)知,形成品牌社群和粉絲效應(yīng)。文化是無形的資產(chǎn),難以被簡單復(fù)制。
3.  "極致的用戶體驗(yàn)和互動 (Ultimate User Experience and Interaction):"
       "超越期待:" 在產(chǎn)品功能之外,
相關(guān)內(nèi)容:
 作者:奎因
創(chuàng)作圈的抄襲丑聞從未停止,從劇本、小說、網(wǎng)文到廣告等無所不包。常有一部火爆作品被發(fā)現(xiàn)和某部原作極為相似,一部現(xiàn)象級的綜藝或真人秀被指出“是抄來的”。
李子柒的視頻在國際走紅后,某越南博主從內(nèi)容、腳本、鏡頭語言、敘事節(jié)奏一路抄到發(fā)型穿著和廚房擺設(shè),甚至“復(fù)制粘貼”了奶奶和小狗。
同樣是觀看量上百萬的視頻,原創(chuàng)費(fèi)盡苦心,抄襲省時省力。

左為李子柒,右為越南博主
用心經(jīng)營的原創(chuàng)方,往往反而被倒逼到“吃力不討好”的困境里。
餐飲界的網(wǎng)紅鮑師傅糕點(diǎn),一度曾用數(shù)十家直營店對抗1000多家山寨店。創(chuàng)始人曾說過:“打假都把我打老了,至少老了十歲”。最絕望的時候,他甚至想換掉“鮑師傅”的品牌名。
當(dāng)某項(xiàng)產(chǎn)品設(shè)計“出圈”后,抄襲者同樣接踵而至。
歷年國際設(shè)計大獎頒布后,從轉(zhuǎn)椅、鑄鐵鍋、玩具挖掘機(jī)到角座閥通通不會被盜版放過。曾拿過獎的NUDE衣帽架國內(nèi)設(shè)計,甚至一度被商家抄襲到失去訂單,工作室險些解體。


作為擁有一系列售價遠(yuǎn)高于行業(yè)平均水平、但市場占有率極高的火爆產(chǎn)品,“戴森熱”一次次被推上了風(fēng)口浪尖,打著“戴森同款”“戴森平替”旗號的山寨家電聞風(fēng)而至,試圖魚目混珠。
哪里有利益,哪里就有山寨。由于直接竊取設(shè)計成果,免去成本極高的研發(fā)過程,價格大幅縮水,山寨產(chǎn)品始終存在一定市場。
但這并不意味著,我們真的進(jìn)入了“原創(chuàng)受挫、山寨橫行”的無奈時代。
實(shí)際上,只有消費(fèi)者的投票,才能決定這個世界究竟會變成什么樣。
市場永遠(yuǎn)需要用核心技術(shù)解決問題的產(chǎn)品
原創(chuàng)和山寨模仿產(chǎn)品,單從目的看就大不相同。
山寨產(chǎn)品通過在功能、外觀設(shè)計、產(chǎn)品包裝或營銷方式上進(jìn)行簡單模仿,試圖蹭熱度收割一波銷售量。
而出色的原創(chuàng)設(shè)計產(chǎn)品,本質(zhì)上是經(jīng)過大量的研發(fā)過程,為易于使用和解決問題而誕生的創(chuàng)新行為。
這與戴森創(chuàng)始人詹姆斯·戴森研發(fā)產(chǎn)品的方法論如出一轍:“找到一個常用物品;分析影響人們順利使用的痛點(diǎn);花精力解決痛點(diǎn)”。
真正能抓住消費(fèi)者且經(jīng)得住考驗(yàn)的好產(chǎn)品,一定不是依靠奪人眼球的宣傳語或看似厲害的數(shù)值,而是解決關(guān)鍵問題的能力與實(shí)際性能表現(xiàn)。
正如零售額約216億元的中國吸塵器龐大市場中,諸多品牌定位各異,而消費(fèi)者期待的好產(chǎn)品,不止是一臺吸力強(qiáng)勁不減弱的吸塵器,還希望它操作方便、結(jié)實(shí)耐用、輕便省力、易于維護(hù)、機(jī)體密封過濾不會造成二次污染,也不會出現(xiàn)或?yàn)V網(wǎng)堵塞難清理等問題。
或許普通消費(fèi)者并不清楚每一項(xiàng)黑科技和新技術(shù)的原理,可能也未曾留意到該產(chǎn)品如何用創(chuàng)新定義了行業(yè)指標(biāo),但他們卻可以直接感受到這件產(chǎn)品好不好用,能不能真正解決問題。
產(chǎn)品的各項(xiàng)參數(shù)很容易“做漂亮”,但產(chǎn)品的細(xì)節(jié)設(shè)計才是影響性能卓越,用戶體驗(yàn)良好的重要因素。
如馬達(dá),作為吸塵器的核心部件,轉(zhuǎn)速絕不是唯一的衡量指標(biāo),同時需要平衡吸力及氣旋分離的能耗配比,以便達(dá)到強(qiáng)勁吸力和吸力持續(xù)不減弱的功效。

戴森Hyperdymium旋速馬達(dá)
戴森的氣旋分離技術(shù),即通過吸塵器內(nèi)部的數(shù)碼馬達(dá)驅(qū)動一陣“龍卷風(fēng)”,分離細(xì)小微塵與潔凈空氣,讓微塵顆粒盡可能全部留在集塵筒中,減少了濾網(wǎng)壓力,避免濾網(wǎng)堵塞問題。

戴森多圓錐氣旋技術(shù)
首要考慮用戶真實(shí)的使用需求,注重用核心技術(shù)解決實(shí)際問題,是領(lǐng)先品牌的共通點(diǎn)。
為了確保產(chǎn)品更能滿足中國消費(fèi)者的要求,戴森針對中國家庭場景做了大量測試。
在上??萍紝?shí)驗(yàn)室,戴森模擬打造了典型的中國家庭場景,使用60種真實(shí)家庭垃圾進(jìn)行測試;為深入中國城市家庭對易被忽視的灰塵及過敏原開展研究,戴森已到訪成都、北京、杭州、深圳等地,旨在更好地為消費(fèi)者提供全方位的居家清潔解決方案。
培養(yǎng)基中生長的菌株
無論深度市場調(diào)研或是大力科技投入,產(chǎn)品思維和工程師精神始終植入在品牌的DNA中,為更好滿足用戶需求而不斷精進(jìn)。
行業(yè)引領(lǐng)者和顛覆者DNA難以被輕易復(fù)制
以產(chǎn)品為主導(dǎo),在技術(shù)研發(fā)上持續(xù)發(fā)力的戴森,長此以往形成了難以復(fù)制的品牌核心競爭力。
這也是為何,諸多模仿者并沒有撼動到它的根基。
那些具有持久生命力的先鋒品牌已經(jīng)明白,反擊抄襲最好的方式,就是在技術(shù)上持續(xù)創(chuàng)新。
無人機(jī)國產(chǎn)品牌大疆,在國際市場上做到了龍頭地位后,曾一度被同行瘋狂模仿。單是大疆口袋云臺相機(jī)一款產(chǎn)品,就有數(shù)家廠商跟風(fēng)山寨。
而大疆打出的王牌,是持續(xù)保持新的創(chuàng)造力。哪怕飛行器很小的一個性能,攝像頭的形狀顏色,都力求在產(chǎn)品性能上更完善,在應(yīng)用領(lǐng)域上“從創(chuàng)新走向新的創(chuàng)新”,并以此成為品牌無法被抄走的靈魂。

也正如戴森對于科技一直以來的突破自我、精益求精。自第一代數(shù)碼馬達(dá)至今,戴森已投資超過3.5 億英鎊研發(fā)數(shù)碼馬達(dá),申請了超過1000多項(xiàng)數(shù)碼馬達(dá)專利。
迄今最強(qiáng)勁的Dyson V11系列無繩吸塵器中使用最新的Hyperdymium旋速馬達(dá),成為戴森無可取代的科技源泉,以及產(chǎn)品技術(shù)迭代與造型突破的核心技術(shù)。
戴森科技所打造出的品牌關(guān)鍵DNA,并非是打著“平替”噱頭的競品通過簡單模仿所能輕易達(dá)到的。
同樣以“高轉(zhuǎn)速馬達(dá)”作為賣點(diǎn),主打性價比的抄襲者,效仿戴森原有的氣旋技術(shù)推出相似解決方案,順帶對戴森獨(dú)特的外形、配件、甚至廣告風(fēng)格進(jìn)行“山寨”,但卻始終無法復(fù)制戴森“從產(chǎn)品本身出發(fā),解決實(shí)際問題”的內(nèi)核驅(qū)動力。

戴森數(shù)碼馬達(dá)專利技術(shù)戴森數(shù)碼馬達(dá)專利技術(shù)
戴森對頂級研發(fā)隊(duì)伍的搭建以及25億英鎊的巨額資金投入,都是為了推動技術(shù)研發(fā)這一巨大的輪盤連續(xù)不斷地高效運(yùn)轉(zhuǎn)。
在馬來西亞、新加坡、菲律賓和英國設(shè)置有研發(fā)和測試中心的戴森,擁有6000多名工程師和科學(xué)家的研發(fā)團(tuán)隊(duì),致力于持續(xù)研發(fā)固態(tài)電池,高速數(shù)碼馬達(dá),視覺系統(tǒng),機(jī)器學(xué)習(xí)技術(shù)及人工智能的創(chuàng)新技術(shù),并專門設(shè)置了規(guī)模領(lǐng)先的機(jī)器人技術(shù)研發(fā)團(tuán)隊(duì)。

戴森研發(fā)中心
從問題出發(fā)開啟產(chǎn)品研發(fā)流程的工程師團(tuán)隊(duì),會花費(fèi)幾個月的時間,致力于為具體的使用問題研發(fā)出最徹底的解決方案,從不會被所謂解決方案“應(yīng)該”有的樣子墨守成規(guī)。
哪怕是戴森新潮的外觀設(shè)計,也不是徒有其表的“另類審美”,追根溯源依然建立在革命性技術(shù)的基礎(chǔ)上,為消費(fèi)者帶來使用效果的實(shí)質(zhì)性轉(zhuǎn)變。
曾經(jīng)在社交圈掀起“戴森浪潮”的吹風(fēng)機(jī),以核心科技實(shí)現(xiàn)了吹風(fēng)機(jī)造型和使用感的顛覆。
戴森把馬達(dá)從機(jī)身尾部挪到了手柄處,高效地將空氣推到一個環(huán)形的放大器中,與Air Amplifier氣流倍增技術(shù)合作,兩者結(jié)合運(yùn)作噴射出三倍強(qiáng)勁氣流,滿足了快速干發(fā)對于氣流的需求,也避免了頭發(fā)被纏繞的問題。

戴森吹風(fēng)機(jī)
戴森新發(fā)布的Omni-glide萬向吸塵器亦是如此。
外形上,它創(chuàng)造性地將氣旋、馬達(dá)、濾網(wǎng)和手柄集于一體并排列于直線機(jī)身,美觀簡潔且機(jī)身體積更小巧;功能上,氣流以直線方式通過機(jī)身,避免氣流損耗,進(jìn)一步提升吸塵及塵氣分離表現(xiàn)。配合點(diǎn)按式電源開關(guān),還可隨心變換手持姿勢,方便深入家具底部及縫隙等狹小空間,讓清潔體驗(yàn)更為便捷輕松。

戴森Omni-glide萬向吸塵器
設(shè)計出對使用體驗(yàn)起關(guān)鍵作用的產(chǎn)品細(xì)節(jié),屬于行業(yè)引領(lǐng)者和顛覆者的深度命題。
當(dāng)同行競品還在亦步亦趨地模仿和山寨,有創(chuàng)新力的品牌又向著顛覆性再造的方向進(jìn)發(fā)。
如同曾面臨過國際市場廉價仿造品威脅的瑞士軍刀,甚至一度被抄襲到危及生存,而維氏公司在原有功能基礎(chǔ)上進(jìn)行創(chuàng)新設(shè)計,為軍刀裝備了激光教鞭、閃存驅(qū)動器等新功能,以滿足新時代消費(fèi)者學(xué)習(xí)和娛樂的多重要求。

而基于對中國現(xiàn)有家庭環(huán)境與消費(fèi)者生活方式的洞察,戴森也推出了多款迎合中國市場的科技產(chǎn)品,滿足不同群體的細(xì)分需求。
V11 Absolute Extra無繩吸塵器,擁有戴森史上最全的12款吸頭與配件,全面覆蓋整屋3D深度清潔,適合如養(yǎng)寵人士及有娃家庭。
Digital Slim 輕量無繩吸塵器,輕量級但吸塵性能不妥協(xié),能夠減輕新銀發(fā)族、都市女性的家務(wù)負(fù)擔(dān)。
Omni-glide萬向吸塵器,主打靈活輕巧,貼合中國年輕群體在緊湊居住空間、復(fù)雜家居環(huán)境里的碎片化清潔習(xí)慣。
配件設(shè)計也充分貼合中國家庭特色。軟絨滾筒吸頭專為中國家庭常見的硬質(zhì)地面設(shè)計,軟絨尼龍材質(zhì)有助吸除大顆粒碎屑并呵護(hù)硬質(zhì)地面,碳纖維刷毛可以有效中和靜電并吸除微塵。
窄縫照明吸頭適合清除昏暗窄縫處的灰塵。底部轉(zhuǎn)換頭不用彎腰即可清潔低處空間。
如今,已經(jīng)不僅是單純銷售某一件或某一類產(chǎn)品的時代,任何一件“能火起來”的原創(chuàng)產(chǎn)品里,都深刻蘊(yùn)含著為大眾提供高質(zhì)量生活方式的解決方案。
倘若走紅后沒有強(qiáng)大的核心實(shí)力為光環(huán)持續(xù)蓄能,“大火”之后,往往是“糊”的結(jié)局。
在行業(yè)競爭激烈、消費(fèi)選擇多樣、抄襲者圍剿的局面下,中國消費(fèi)者持續(xù)“真香”戴森并不容易。
但經(jīng)過市場和時間檢驗(yàn),它終究得到了肯定。
永遠(yuǎn)把“完善用戶體驗(yàn)”和“解決實(shí)際問題”放在最重要地位上,是任何行業(yè)中的頭部品牌能沖破“被抄襲”重圍的核心。
沒有例外。

	    	微信掃一掃打賞
	    
	    	支付寶掃一掃打賞